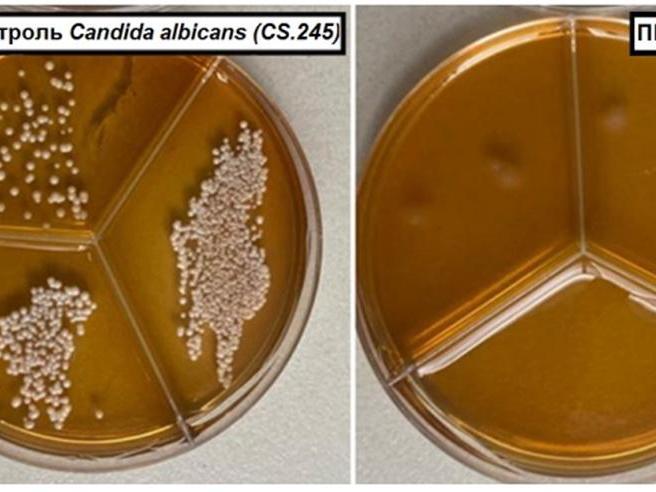

Tomsk Scientists Create Russia's First Antimicrobial Food Film

The antimicrobial food film has been successfully tested in laboratory conditions against various pathogens.
Scientists in Tomsk have created the first antimicrobial food film in the country. Under it, harmful bacteria and fungi do not multiply, and it is completely safe for humans, according to the press service of Tomsk State University.
This innovative packaging prevents the multiplication of harmful microorganisms, enhancing food safety and shelf life.
Food film made of polypropylene is ideal for packaging products. It is inexpensive and reliably protects food from moisture and oxygen. However, as scientists have found, it also has drawbacks. For example, bacteria can survive on its surface for weeks, which reduces the shelf life of products and creates risks for people. The solution was to incorporate antimicrobial nanoparticles of silver and zinc oxide into the material.
The food film has already been tested against bacteria Staphylococcus aureus (golden staph) and yeast-like fungi Candida albicans. Bacteria and fungi were first applied to composite films, and then covered with sterile film. The result showed a significant reduction in microbial growth.
«To date, domestic industry does not have serial large-scale production of antimicrobial packaging materials for the food sector. At the same time, manufacturers are very interested in such packaging, as increasing the shelf life of products even by one day will lead to a significant reduction in economic losses,» the press service of TSU quotes research associate Olga Bakina from the laboratory of nanotechnology in metallurgy at the Faculty of Physics and Technology of TSU.
She added that their development is already patented and ready for real production.


